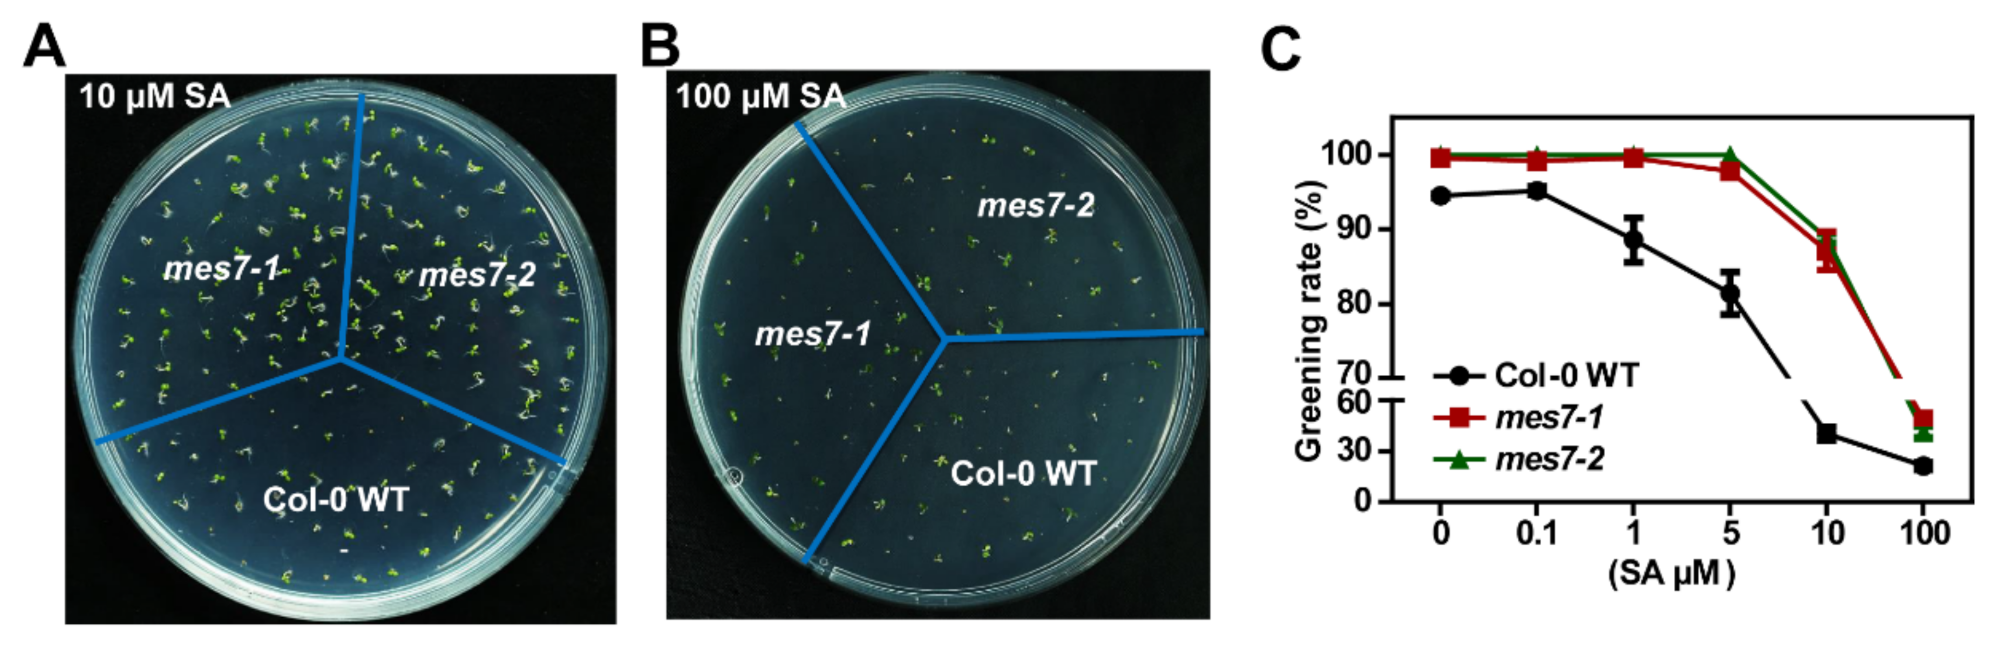
Plants 10 00903 g004 Plants 10 00903 g004

MES7 Modulates Seed Germination via Regulating Salicylic Acid Content in Arabidopsis
Abstract
1. Introduction
2. Results
2.1. MES7 Accumulation Deceases in Imbibed Seeds
2.2. Identification of MES7 Mutants
2.3. Dysregulation of MES7 Affects Seed Germination under Normal Condition
2.4. Exogenous SA Application Rescues the Germination Differences in MES7 Deficient Plants
2.5. MES7 SA-Dependently Facilitates Seed Germination under Saline Condition
3. Discussion
4. Materials and Methods
4.1. Plant Material and Growth Conditions
4.2. Identification of T-DNA Insertions
4.3. RNA Extraction
4.4. Reverse Transcription and qRT–PCR
4.5. Subcellular Localization
4.6. Analysis of SA and IAA Accumulation
4.7. Statistical Analysis
5. Conclusions
Supplementary Materials
Author Contributions
Funding
Data Availability Statement
Acknowledgments
Conflicts of Interest
References
- Li, W.; Tran, L.S. Effects of ethylene on seed germination of halophyte plants under salt stress. Methods Mol. Biol. 2017, 1573, 253–259. [Google Scholar] [PubMed]
- Horvath, E.; Szalai, G.; Janda, T. Induction of abiotic stress tolerance by salicylic acid signaling. J. Plant. Growth Regul. 2007, 26, 290–300. [Google Scholar] [CrossRef]
- Dong, C.J.; Li, L.; Shang, Q.M.; Liu, X.Y.; Zhang, Z.G. Endogenous salicylic acid accumulation is required for chilling tolerance in cucumber (Cucumis sativus L.) seedlings. Planta 2014, 240, 687–700. [Google Scholar] [CrossRef] [PubMed]
- Zhang, Y.; Li, X. Salicylic acid: Biosynthesis, perception, and contributions to plant immunity. Curr. Opin. Plant Biol. 2019, 50, 29–36. [Google Scholar] [CrossRef] [PubMed]
- Mariana, R.S.V.; Javier, P. Salicylic acid beyond defence: Its role in plant growth and development. J. Exp. Bot. 2011, 10, 10. [Google Scholar]
- Huang, Y.; Sun, M.M.; Ye, Q.; Wu, X.Q.; Wu, W.H.; Chen, Y.F. Abscisic acid modulates seed germination via ABA insensitive5-mediated PHOSPHATE1. Plant Physiol. 2017, 175, 1661–1668. [Google Scholar] [CrossRef]
- Bi, L.; Weng, L.; Jiang, Z.; Xiao, H. The tomato IQD gene SUN24 regulates seed germination through ABA signaling pathway. Planta 2018, 248, 919–931. [Google Scholar] [CrossRef]
- Shu, K.; Liu, X.D.; Xie, Q.; He, Z.H. Two faces of one seed: Hormonal regulation of dormancy and germination. Mol. Plant 2016, 9, 34–45. [Google Scholar] [CrossRef]
- Shuai, H.; Meng, Y.; Luo, X.; Chen, F.; Zhou, W.; Dai, Y.; Qi, Y.; Du, J.; Yanh, F.; Liu, J.; et al. Exogenous auxin represses soybean seed germination through decreasing the gibberellin/abscisic acid (GA/ABA) ratio. Sci. Rep. 2017, 7, 12620. [Google Scholar] [CrossRef]
- Shu, K.; Qi, Y.; Chen, F.; Meng, Y.; Luo, X.; Shuai, H.; Zhou, W.; Ding, J.; Du, J.; Liu, J.; et al. Salt stress represses soybean seed germination by negatively regulating GA biosynthesis while positively mediating ABA biosynthesis. Front. Plant Sci. 2017, 8, 1372. [Google Scholar] [CrossRef]
- Xiong, W.; Ye, T.; Yao, X.; Liu, X.; Ma, S.; Chen, X.; Chen, M.L.; Feng, Y.Q.; Wu, J. The dioxygenase GIM2 functions in seed germination by altering gibberellin production in Arabidopsis. J. Integr. Plant Biol. 2018, 60, 276–291. [Google Scholar] [CrossRef]
- Linkies, A.; Leubner-Metzger, G. Beyond gibberellins and abscisic acid: How ethylene and jasmonates control seed germination. Plant Cell Rep. 2012, 31, 253–270. [Google Scholar] [CrossRef]
- Hermann, K.; Meinhard, J.; Dobrev, P.; Linkies, A.; Pesek, B.; Hess, B.; Machackova, I.; Fischer, U.; Leubner-Metzger, G. 1-aminocyclopropane-1-carboxylic acid and abscisic acid during the germination of sugar beet (Beta vulgaris L.): A comparative study of fruits and seeds. J. Exp. Bot. 2007, 58, 3047–3060. [Google Scholar] [CrossRef]
- Lee, S.; Kim, S.G.; Park, C.M. Salicylic acid promotes seed germination under high salinity by modulating antioxidant activity in Arabidopsis. New Phytol. 2010, 188, 626–637. [Google Scholar] [CrossRef]
- Xie, Z.; Zhang, Z.L.; Hanzlik, S.; Cook, E.; Shen, Q.J. Salicylic acid inhibits gibberellin-induced alpha-amylase expression and seed germination via a pathway involving an abscisic-acid-inducible WRKY gene. Plant Mol. Biol. 2007, 64, 293–303. [Google Scholar] [CrossRef]
- Loc Rajjou, M.B.; Huguet, R.; Robin, C.; Moreau, A.; Job, C.; Job, D. Proteomic investigation of the effect of salicylic acid on Arabidopsis seed germination and establishment of early defense mechanisms. Plant Physiol. 2006, 141, 910–923. [Google Scholar] [CrossRef]
- Alonso-Ramirez, A.; Rodriguez, D.; Reyes, D.; Jimenez, J.A.; Nicolas, G.; Lopez-Climent, M.; Gomez-Cadenas, A.; Nicolas, C. Evidence for a role of gibberellins in salicylic acid-modulated early plant responses to abiotic stress in Arabidopsis seeds. Plant Physiol. 2009, 150, 1335–1344. [Google Scholar] [CrossRef]
- Liu, J.; Li, L.; Yuan, F.; Chen, M. Exogenous salicylic acid improves the germination of Limonium bicolor seeds under salt stress. Plant Signal. Behav. 2019, 14, 1644595. [Google Scholar] [CrossRef]
- Dempsey, D.A.; Klessig, D.F. How does the multifaceted plant hormone salicylic acid combat disease in plants and are similar mechanisms utilized in humans? BMC Biol. 2017, 15, 23. [Google Scholar] [CrossRef]
- Lefevere, H.; Bauters, L.; Gheysen, G. Salicylic acid biosynthesis in plants. Front. Plant Sci. 2020, 11, 338. [Google Scholar] [CrossRef]
- George Thompson, A.M.; Iancu, C.V.; Neet, K.E.; Dean, J.V.; Choe, J.Y. Differences in salicylic acid glucose conjugations by ugt74f1 and UGT74F2 from Arabidopsis thaliana. Sci. Rep. 2017, 7, 46629. [Google Scholar] [CrossRef]
- Vlot, A.C.; Dempsey, D.A.; Klessig, D.F. Salicylic acid, a multifaceted hormone to combat disease. Annu. Rev. Phytopathol. 2009, 47, 177–206. [Google Scholar] [CrossRef]
- Li, Y.X.; Zhang, W.; Dong, H.X.; Liu, Z.Y.; Ma, J.; Zhang, X.Y. Salicylic acid in Populus tomentosa is a remote signalling molecule induced by Botryosphaeria dothidea infection. Sci. Rep. 2018, 8, 14059. [Google Scholar] [CrossRef]
- Park, S.W.; Kaimoyo, E.; Kumar, D.; Mosher, S.; Klessig, D.F. Methyl salicylate is a critical mobile signal for plant systemic acquired resistance. Science 2007, 318, 113–116. [Google Scholar] [CrossRef]
- Kachroo, P.; Liu, H.; Kachroo, A. Salicylic acid: Transport and long-distance immune signaling. Curr. Opin. Virol. 2020, 42, 53–57. [Google Scholar] [CrossRef]
- Yang, Y.; Xu, R.; Ma, C.J.; Vlot, A.C.; Klessig, D.F.; Pichersky, E. Inactive methyl indole-3-acetic acid ester can be hydrolyzed and activated by several esterases belonging to the atmes esterase family of Arabidopsis. Plant. Physiol. 2008, 147, 1034–1045. [Google Scholar] [CrossRef]
- Vlot, A.C.; Liu, P.P.; Cameron, R.K.; Park, S.W.; Yang, Y.; Kumar, D.; Zhou, F.; Padukkavidana, T.; Gustafsson, C.; Pichersky, E.; et al. Identification of likely orthologs of tobacco salicylic acid-binding protein 2 and their role in systemic acquired resistance in Arabidopsis thaliana. Plant. J. 2008, 56, 445–456. [Google Scholar] [CrossRef]
- Li, H.; Pu, H. Crystal structure of methylesterase family member 16 (MES16) from Arabidopsis thaliana. Biochem. Biophys. Res. Commun. 2016, 474, 226–231. [Google Scholar] [CrossRef]
- Manosalva, P.M.; Park, S.W.; Forouhar, F.; Tong, L.; Fry, W.E.; Klessig, D.F. Methyl esterase 1 (StMES1) is required for systemic acquired resistance in potato. Mol. Plant Microbe Interact. 2010, 23, 1151–1163. [Google Scholar] [CrossRef]
- Preston, J.; Tatematsu, K.; Kanno, Y.; Hobo, T.; Kimura, M.; Jikumaru, Y.; Yano, R.; Kamiya, Y.; Nambara, E. Temporal expression patterns of hormone metabolism genes during imbibition of Arabidopsis thaliana seeds: A comparative study on dormant and non-dormant accessions. Plant Cell Physiol. 2009, 50, 1786–1800. [Google Scholar] [CrossRef] [PubMed]
- Lee, S.; Park, C.M. Modulation of reactive oxygen species by salicylic acid in Arabidopsis seed germination under high salinity. Plant Signal. Behav. 2010, 5, 1534–1536. [Google Scholar] [CrossRef] [PubMed]
- Rao, M.V.; Paliyath, G.; Ormrod, D.P.; Murr, D.P.; Watkins, C.B. Influence of salicylic acid on H2O2 production, oxidative stress, and H2O2-metabolizing enzymes. Salicylic acid-mediated oxidative damage requires H2O2. Plant Physiol. 1997, 115, 137–149. [Google Scholar] [CrossRef] [PubMed]
- Harfouche, A.L.; Rugini, E.; Mencarelli, F.; Botondi, R.; Muleo, R. Salicylic acid induces H2O2 production and endochitinase gene expression but not ethylene biosynthesis in Castanea sativa in vitro model system. J. Plant. Physiol. 2008, 165, 734–744. [Google Scholar] [CrossRef]
- Borsani, O.; Valpuesta, V.; Botella, M.A. Evidence for a role of salicylic acid in the oxidative damage generated by nacl and osmotic stress in Arabidopsis seedlings. Plant. Physiol. 2001, 126, 1024–1030. [Google Scholar] [CrossRef]
- Ahmed, W.; Imran, M.; Yaseen, M.; Haq, T.U.; Jamshaid, M.U.; Rukh, S.; Ikram, R.M.; Ali, M.; Ali, A.; Maqbool, M. Role of salicylic acid in regulating ethylene and physiological characteristics for alleviating salinity stress on germination, growth and yield of sweet pepper. Peer J. 2020, 8, 8475. [Google Scholar] [CrossRef]
- Ding, P.; Ding, Y. Stories of salicylic acid: A plant defense hormone. Trends Plant Sci. 2020, 25, 549–565. [Google Scholar] [CrossRef]
- Nawrath, C.; Metraux, J.P. Salicylic acid induction-deficient mutants of Arabidopsis express PR-2 and PR-5 and accumulate high levels of camalexin after pathogen inoculation. Plant Cell 1999, 11, 1393–1404. [Google Scholar]
- Delaney, T.P.; Uknes, S.; Vernooij, B.; Friedrich, L.; Weymann, K.; Negrotto, D.; Gaffney, T.; Gut-Rella, M.; Kessmann, H.; Ward, E.; et al. A central role of salicylic acid in plant disease resistance. Science 1994, 266, 1247–1250. [Google Scholar] [CrossRef]
- Alonso, J.M.; Stepanova, A.N.; Leisse, T.J.; Kim, C.J.; Chen, H.; Shinn, P.; Stevenson, D.K.; Zimmerman, J.; Barajas, P.; Cheuk, R. Genome-wide insertional mutagenesis of Arabidopsis thaliana. Science 2003, 301, 653–657. [Google Scholar] [CrossRef]
- Meng, L.; Feldman, L. A rapid TRIzol-based two-step method for DNA-free RNA extraction from Arabidopsis siliques and dry seeds. Biotechnol. J. 2010, 5, 183–186. [Google Scholar] [CrossRef]
- Liu, Y.; Gao, W.; Wu, S.; Lu, L.; Chen, Y.; Guo, J.; Men, S.; Zhang, X. AtXRN4 affects the turnover of chosen miRNA * s in Arabidopsis. Plants 2020, 9, 362. [Google Scholar] [CrossRef] [PubMed]
- Earley, K.W.; Haag, J.R.; Pontes, O.; Opper, K.; Juehne, T.; Song, K.; Pikaard, C.S. Gateway-compatible vectors for plant functional genomics and proteomics. Plant J. 2006, 45, 616–629. [Google Scholar] [CrossRef] [PubMed]
- Ye, R.; Wang, W.; Iki, T.; Liu, C.; Wu, Y.; Ishikawa, M.; Zhou, X.; Qi, Y. Cytoplasmic assembly and selective nuclear import of Arabidopsis Argonaute4/siRNA complexes. Mol. Cell 2012, 46, 859–870. [Google Scholar] [CrossRef] [PubMed]
- Qi, J.; Sun, G.; Wang, L.; Zhao, C.; Hettenhausen, C.; Schuman, M.C.; Baldwin, I.T.; Li, J.; Song, J.; Liu, Z. Oral secretions from Mythimna separata insects specifically induce defence responses in maize as revealed by high-dimensional biological data. Plant Cell Environ. 2016, 39, 1749–1766. [Google Scholar] [CrossRef]
- Wu, J.; Hettenhausen, C.; Meldau, S.; Baldwin, I.T. Herbivory rapidly activates MAPK signaling in attacked and unattacked leaf regions but not between leaves of Nicotiana attenuata. Plant Cell 2007, 19, 1096–1122. [Google Scholar] [CrossRef]
- Kramer, M.H.; Paparozzi, E.T.; Stroup, W.W. Best practices for presenting statistical information in a research article. HortScience 2019, 54, 1605–1609. [Google Scholar] [CrossRef]

Publisher’s Note: MDPI stays neutral with regard to jurisdictional claims in published maps and institutional affiliations. |
© 2021 by the authors. Licensee MDPI, Basel, Switzerland. This article is an open access article distributed under the terms and conditions of the Creative Commons Attribution (CC BY) license (https://creativecommons.org/licenses/by/4.0/).
Share and Cite
Gao, W.; Liu, Y.; Huang, J.; Chen, Y.; Chen, C.; Lu, L.; Zhao, H.; Men, S.; Zhang, X. MES7 Modulates Seed Germination via Regulating Salicylic Acid Content in Arabidopsis. Plants 2021, 10, 903. https://doi.org/10.3390/plants10050903
Gao W, Liu Y, Huang J, Chen Y, Chen C, Lu L, Zhao H, Men S, Zhang X. MES7 Modulates Seed Germination via Regulating Salicylic Acid Content in Arabidopsis. Plants. 2021; 10(5):903. https://doi.org/10.3390/plants10050903
Chicago/Turabian StyleGao, Wenrui, Yan Liu, Juan Huang, Yaqiu Chen, Chen Chen, Lu Lu, Hongwei Zhao, Shuzhen Men, and Xiaoming Zhang. 2021. "MES7 Modulates Seed Germination via Regulating Salicylic Acid Content in Arabidopsis" Plants 10, no. 5: 903. https://doi.org/10.3390/plants10050903
APA StyleGao, W., Liu, Y., Huang, J., Chen, Y., Chen, C., Lu, L., Zhao, H., Men, S., & Zhang, X. (2021). MES7 Modulates Seed Germination via Regulating Salicylic Acid Content in Arabidopsis. Plants, 10(5), 903. https://doi.org/10.3390/plants10050903

